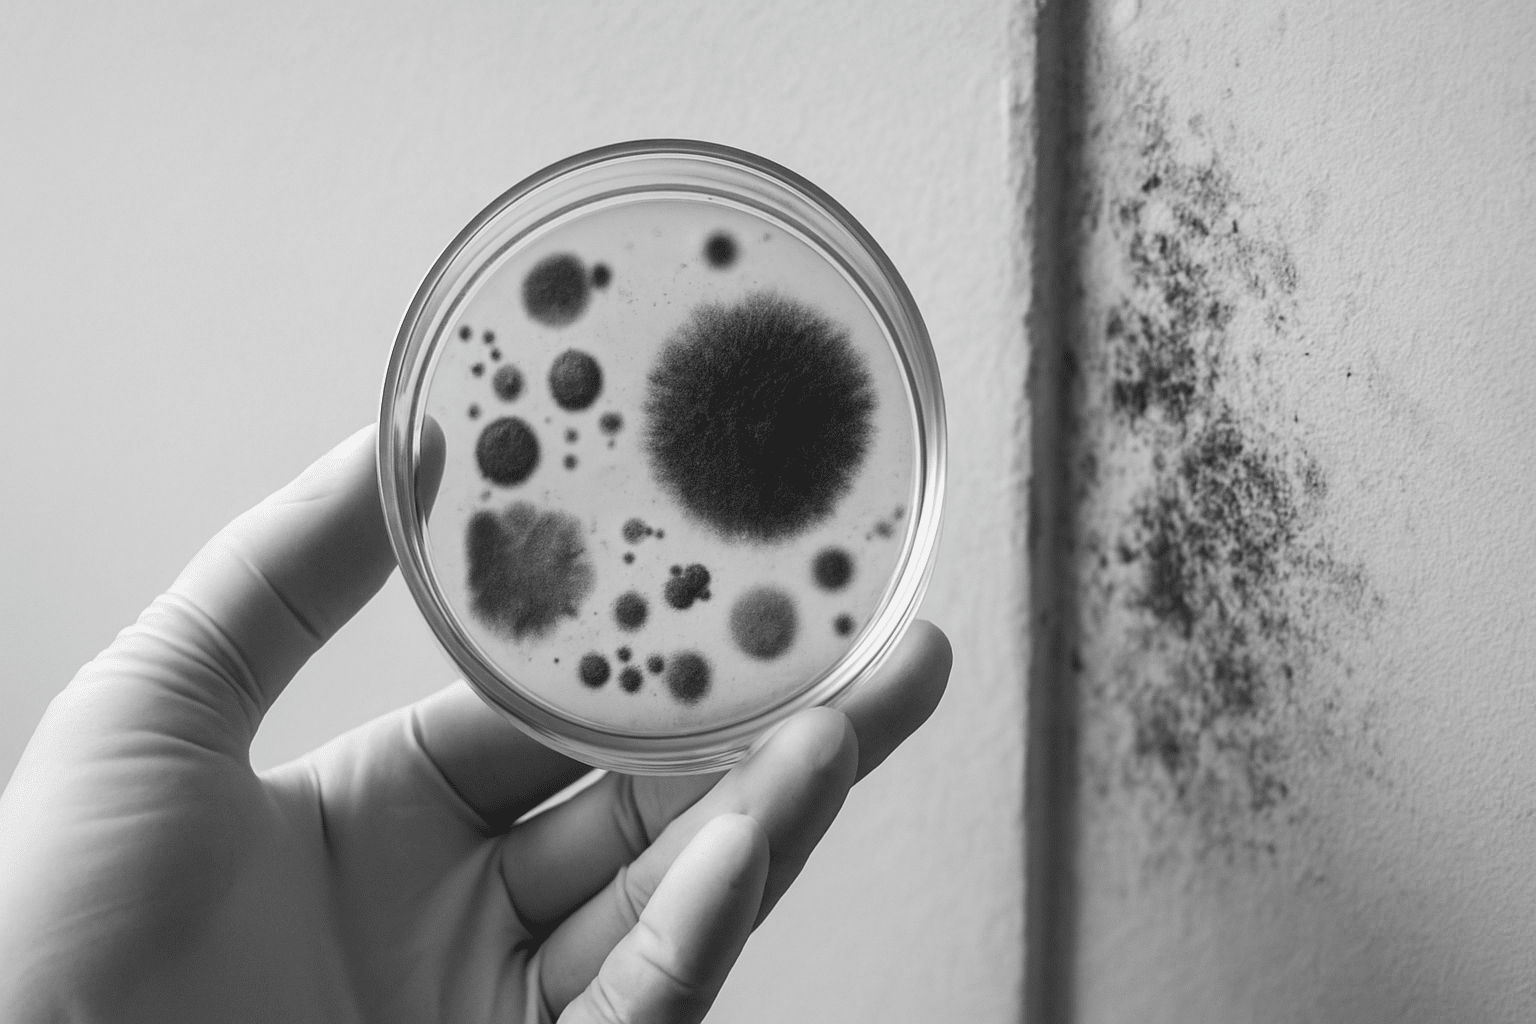

Table of Contents
Finding Reliable Mold Mycotoxin Test Near Me in Dubai
When searching for a mold mycotoxin test near me in Dubai, it’s essential to understand not only where to find these services but also what differentiates quality testing from inadequate methods. Mold mycotoxins, the toxic byproducts released by certain mold species, pose a significant health risk if left undetected and untreated. Whether in residential buildings, offices in Business Bay, or villas in Arabian Ranches, comprehensive testing helps safeguard occupants against respiratory issues, allergies, and even severe long-term health complications. Finding a reliable mold mycotoxin test near me in Dubai is the first step.
Dubai’s unique climate, combined with rapid urban development, creates an environment where mold growth can thrive, especially in areas with poor ventilation or water damage. This makes timely, accurate mold mycotoxin testing critical for maintaining a healthy indoor environment. By focusing on local testing providers and understanding Dubai-specific standards and regulations, residents and businesses can ensure they receive dependable assessments with actionable results. This often involves choosing a provider for a mold mycotoxin test near me.
Why Choose Local Testing Services in Dubai?
Opting for a local facility or specialist offering mold mycotoxin testing has distinct advantages. Dubai-based labs and service providers are familiar with the city’s climate challenges, building structures, and the applicable regulatory framework overseen by Dubai Municipality and the Dubai Health Authority (DHA). Consequently, these providers tailor their testing procedures to align perfectly with Dubai’s environmental conditions and compliance requirements such as the Dubai Fire & Life Safety Code. This local expertise is vital when seeking a mold mycotoxin test near me.
- Expedited sample collection and quick turnaround times, essential for preventing mold proliferation.
- Knowledge of common mold strains and mycotoxins prevalent in Dubai’s indoor environments.
- Use of approved methodologies adhering to guidelines issued by Dubai Municipality or DHA.
- Expert advice on remediation practices applicable to Dubai’s climate and building codes.
For example, commercial districts like Downtown Dubai or Dubai Marina often deal with high-rise buildings where moisture intrusion could lead to hidden mold growth. Local specialists understand these unique factors and conduct comprehensive air, surface, and bulk sampling that can reveal even concealed mycotoxin contamination. This makes their mold mycotoxin test near me invaluable.
Understanding Mold Mycotoxin Testing Processes in Dubai
Testing for mold mycotoxins involves detecting the toxic substances that molds produce, which can be invisible to the naked eye but harmful when inhaled or contacted. The typical mold mycotoxin test near me in Dubai includes a series of steps that maximize accuracy and reliability:
- Preliminary Inspection: Technicians conduct a visual survey of the premises, noting areas prone to moisture or previous water damage, such as basements in Downtown Dubai or water-exposed walls in apartment complexes at Jumeirah Lake Towers.
- Sample Collection: Samples can be drawn from air, dust, surface swabs, or building materials. Advanced equipment, like spore traps and surface lysimeters, are commonly used by Dubai-based labs to ensure contaminants are efficiently captured.
- Laboratory Analysis: Dubai laboratories equipped with liquid chromatography-mass spectrometry (LC-MS) or enzyme-linked immunosorbent assay (ELISA) techniques analyze the samples to detect mycotoxins such as aflatoxins, ochratoxins, and trichothecenes.
- Report and Recommendations: The final report outlines the presence or absence of mycotoxins, identifies contamination hotspots, and offers remediation strategies. Reports comply with Dubai Municipality’s environmental health guidelines, ensuring they meet local standards for safety and indoor air quality.
It is advisable to select a provider who offers end-to-end services from sample collection to detailed reporting combined with expert consultation. This holistic approach ensures that once a mold hazard is identified, clients receive clear guidance tailored to Dubai’s unique building environment including step-by-step removal or containment plans. Securing a comprehensive mold mycotoxin test near me is key to this process.
Common Locations in Dubai Prompting Mold Mycotoxin Testing
Some types of properties or locations are more at risk and often prompt the need for mold mycotoxin test near me in Dubai. These hotspots include:
- Water-Damaged Residences: Areas like Meadows or Nad Al Sheba often experience water intrusion during rare flooding or plumbing leaks, making them susceptible.
- Newly Renovated Offices: In Business Bay, renovations sometimes disturb hidden mold colonies, necessitating follow-up testing.
- Buildings with Poor Ventilation: Villas in Arabian Ranches with closed windows during hot months and heavy AC reliance often trap humidity, creating an ideal mold environment.
- Schools and Healthcare Facilities: Given their high occupancy and vulnerability, places like clinics and nurseries in Downtown Dubai demand stringent air quality checks under DHA protocols.
Early identification through testing can prevent costly health impacts and align with Dubai Health & Safety regulations that emphasize indoor air quality management. For these critical environments, a prompt mold mycotoxin test near me is indispensable.
How to Prepare for a Mold Mycotoxin Test in Dubai
To ensure accurate results when scheduling a mold mycotoxin test near me in Dubai, consider a few preparation tips:
- Avoid Cleaning or Disturbing Suspected Areas: Prior to the test, avoid wiping surfaces or disturbing dust in areas of concern, as this can affect sample integrity.
- Provide Access to Testing Areas: Ensure technicians can access all relevant rooms, including storage areas, HVAC ducts, and crawl spaces common in Dubai’s apartment designs.
- Limit Indoor Airflows: Maintain normal ventilation prior to testing, but avoid opening windows or using fans during air sampling to prevent sample contamination.
- Document Symptoms or Observations: Share any health symptoms, visible mold spots, or odors noticed by occupants with the testing provider for targeted inspection.
Following these best practices contributes to a more precise diagnosis and effective remediation process adhering to Dubai Municipality standards. It ensures your mold mycotoxin test near me yields the most reliable results.
Choosing a Trusted Provider for Mold Mycotoxin Test Near Me in Dubai
With many companies offering mold testing services in Dubai, selecting a reliable and certified provider is paramount. When vetting local laboratories or service companies for a mold mycotoxin test near me, keep the following criteria in mind:
- Accreditation and Certifications: Verify that the lab or technician holds approvals from Dubai Municipality, DHA, or recognized Dubai-based accreditation bodies.
- Experience with Dubai-Specific Environments: Experienced providers understand local mold risks and offer tailored testing solutions rather than generic services.
- Comprehensive Reporting: Look for detailed reports that explain findings clearly and provide actionable recommendations in line with Dubai’s health and safety codes.
- Post-Test Support: A good mold mycotoxin test company in Dubai will offer follow-up consultations and remediation guidance, helping clients minimize health risks effectively.
For residents and businesses within Dubai, companies like Saniservice, offering a specialized mold mycotoxin test near me, ensure locally optimized testing protocols and compliance with all relevant authorities. By selecting such a partner, you ensure your mold mycotoxin test near me in Dubai meets the highest standards.
Final Thoughts on Mold Mycotoxin Testing in Dubai
Locating and scheduling a thorough mold mycotoxin test near me in Dubai is a crucial step to safeguarding indoor health against hidden mold threats common in the city’s diverse building stock. Understanding the importance of local expertise, adherence to Dubai Municipality and DHA regulations, and comprehensive testing methodologies empowers residents and business owners alike to act decisively against mold contamination.
Whether you reside in a luxury penthouse in Dubai Marina or manage an office tower in Downtown Dubai, timely mold mycotoxin testing ensures your indoor air quality remains safe, your occupants healthy, and your property compliant with Dubai’s stringent health and safety standards. Consider scheduling your mold mycotoxin test near me today.
For a comprehensive understanding of indoor air quality and how to schedule an expert mold mycotoxin test near me, consider reaching out to accredited firms such as Indoor Sciences Dubai.